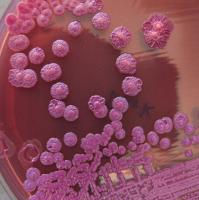

- Tiziano Fusella
Articolo
NEW YORK - Gli ambientalisti degli Stati Uniti sono in allarme per una fuga di elementi radioattivi riscontrata nell’impianto nucleare di Indian Point, nello stato di New York. Chiedono, per ora, la chiusura temporanea dell’impianto durante le fasi di accertamento, che da sabato scorso si stanno succedendo nel tentativo di capire da dove proviene... Continua
Articolo
Una speranza per fermare il virus Zika potrebbe arrivare dall’India, paese che da sempre fa i conti con malattie trasmesse dalle zanzare quali malaria, dengue e chikungunya.
Il biologo Krishna Ella non si aspettava di possedere l’arma per affrontare l’emergenza divenuta planetaria. Ebbene, il suo laboratorio di ricerca, il Bharat Biotech, è... Continua
Articolo
GIAPPONE - Anche quest’anno la “polpetta assassina” di capodanno ha mietuto le sue vittime. La Nhk, la principale tv giapponese, ha dato la notizia che otto persone sono morte nella solo Tokyo per essersi affogati con i “mochi” durante i giorni di festa che in Giappone vanno dall’uno al tre gennaio. Altre 18 persone sono state ricoverate in... Continua
Articolo
Ricetta tipica toscana. Una zuppa "super sana". Fin dall’antichità viene preparata con pane raffermo e ortaggi di stagione. Come il cavolo nero, ad esempio, ricchissimo di antiossidanti, sali minerali e vitamine (inclusa la C, indispensabile in questo periodo). Unito alle proteine dei cannellini, migliorano il profilo nutrizionale della ribollita... Continua
Articolo
INDIA - Negli ultimi giorni la notizia di un nuovo batterio particolarmente virulento, ma già conosciuto negli ambienti di ricerca, sta rimbalzando sulle riviste specializzate. La melioidosi, una malattia altamente contagiosa, è ampiamente diffusa in India, secondo un nuovo rapporto dei ricercatori dell'Università di Oxford. Se non curata in tempo... Continua
Articolo
Le mascherine sui volti delle persone sono una delle prime cose che si notano camminando per le strade di Tokyo. Per l'aria inquinata? Certamente no, visto che la capitale giapponese, nonostante i quasi 15 milioni di abitanti (35 milioni se si considerano le tre prefetture limitrofe), non presenta livelli di inquinamento più alti di una città come... Continua
Articolo
PISA - Il titolo del corso è innocuo e discreto: La nuova Farmacia, tra salute e benessere. Ma quel master in “cosmesi, medicina omeopatica e marketing”, da pochi giorni iniziato all’Università di Pisa, sta scatenando un putiferio nel mondo accademico. Malumori e dissensi che non arrivano solo dall’ateneo toscano. Uno scontro che, oltre a... Continua
Articolo
AVELLINO - Potrebbe essere definita una "mini-TAV" del Sud, in quanto a invasività del progetto. Nelle ultime settimane, poi, si è trasformata in una lotta contro il tempo per concludere i lavori di un’opera per molti "inutile", mentre il cantiere è aperto da quasi nove anni. Se al 31 dicembre non saranno terminati i lavori del tunnel che passa... Continua
Articolo
I prezzi bassi della frutta talvolta nascondono un prezzo ancora più alto per la collettività.
Anno dopo anno in Italia sono spariti migliaia di etteari di frutteto. Colpa della crisi, certo, della poca innovazione, e dello strano fenomeno della "globalizzazione della frutta". Che sta penalizzando la qualità.
L'Italia non è solo il... Continua
Articolo
POZZUOLI - «Negli anni ’80 qui all’Anfiteatro Flavio veniva l’Orchestra del San Carlo di Napoli a suonare. Nel 2015 nemmeno un incontro di preghiera. È così che si pensa di valorizzare il patrimonio archeologico?». Se lo chiede Ciro di Francia, da anni impegnato nelle battaglie civili tra le provincia di Napoli e Caserta. In particolare a Pozzuoli... Continua
Categoria
autore
- (-) Remove Tiziano Fusella filter Tiziano Fusella